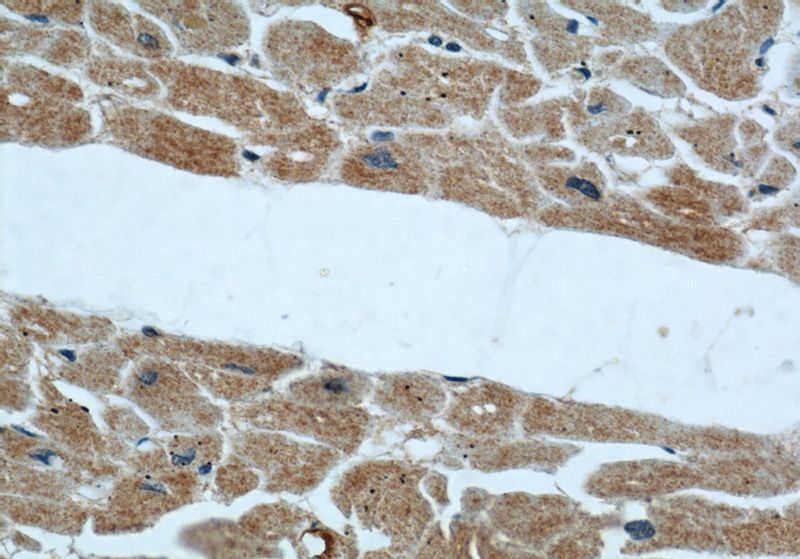
Immunohistochemical of paraffin-embedded human heart using Catalog No:107215(FBLN5 antibody) at dilution of 1:50 (under 40x lens)

-
Product Name
Fibulin 5 antibody
- Documents
-
Description
Fibulin 5 Mouse Monoclonal antibody. Positive WB detected in MCF7 cells, HeLa cells. Positive IHC detected in human heart tissue, human pancreas tissue. Positive IF detected in HeLa cells. Observed molecular weight by Western-blot: 50 kDa
-
Tested applications
ELISA, WB, IHC, IF
-
Species reactivity
Human, Mouse; other species not tested.
-
Alternative names
ARMD3 antibody; DANCE antibody; EVEC antibody; FBLN5 antibody; FIBL 5 antibody; fibulin 5 antibody; FLJ90059 antibody; UP50 antibody; Urine p50 protein antibody
-
Isotype
Mouse IgG1
-
Preparation
This antibody was obtained by immunization of Fibulin 5 recombinant protein (Accession Number: NM_006329). Purification method: Caprylic acid/ammonium sulfate precipitation.
-
Clonality
Monoclonal
-
Formulation
PBS with 0.1% sodium azide and 50% glycerol pH 7.3.
-
Storage instructions
Store at -20℃. DO NOT ALIQUOT
-
Applications
Recommended Dilution:
WB: 1:500-1:5000
IHC: 1:20-1:200
IF: 1:20-1:200
-
Validations

MCF7 cells were subjected to SDS PAGE followed by western blot with Catalog No:107215(FBLN5 antibody) at dilution of 1:500

Immunohistochemical of paraffin-embedded human heart using Catalog No:107215(FBLN5 antibody) at dilution of 1:50 (under 10x lens)
Immunohistochemical of paraffin-embedded human heart using Catalog No:107215(FBLN5 antibody) at dilution of 1:50 (under 40x lens)

Immunofluorescent analysis of (-20oc Ethanol) fixed HeLa cells using Catalog No:107215(FBLN5 Antibody) at dilution of 1:50 and Alexa Fluor 488-congugated AffiniPure Goat Anti-Mouse IgG(H+L)
-
Background
Fibulin-5, also known as EVEC and DANCE, is a extracellular matrix glycoprotein, secreted by various cell types such as vascular smooth muscle cells, fibroblasts and endothelial cells. Structurally, Fibulin-5 contains an Arg-Gly-Asp (RGD) motif and calcium-binding EGF-like domains. It promotes adhesion of endothelial cells through interaction of integrins and the RGD motif. FBLN5 mutations have been described in patients with age-related macular degeneration, as well as being involved in Charcot-Marie-Tooth neuropathies.
-
References
- Hulleman JD, Brown SJ, Rosen H, Kelly JW. A high-throughput cell-based Gaussia luciferase reporter assay for identifying modulators of fibulin-3 secretion. Journal of biomolecular screening. 18(6):647-58. 2013.
- Hwang CF, Shiu LY, Su LJ. Oncogenic fibulin-5 promotes nasopharyngeal carcinoma cell metastasis through the FLJ10540/AKT pathway and correlates with poor prognosis. PloS one. 8(12):e84218. 2013.
Related Products / Services
Please note: All products are "FOR RESEARCH USE ONLY AND ARE NOT INTENDED FOR DIAGNOSTIC OR THERAPEUTIC USE"
